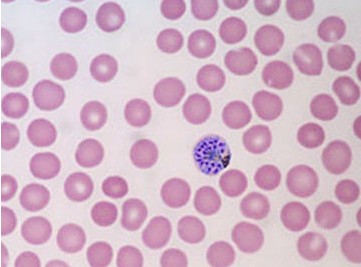

Trong chu kỳ phát triển của ký sinh trùng sốt rét ở cơ thể người, đến giai đoạn ký sinh trùng ký sinh tại hồng cầu máu phát triển thành thể phân liệt (Schizont), nó sẽ phá vở hàng loạt hồng cầu, xâm nhập các hồng cầu mới để tiếp tục thực hiện chu kỳ. Do hồng cầu bị phá hủy nhiều nên bệnh nhân bị mắc bệnh sốt rét thường có triệu chứng bệnh lý thiếu máu và những thay đổi về máu.
Bệnh sốt rét gây thiếu máu và thay đổi về máu
Khi bị mắc bệnh sốt rét, triệu chứng thiếu máu là một biểu hiện bệnh lý hầu hết xảy ra trong tất cả các trường hợp với nhiều mức độ khác nhau. Mức độ thiếu máu phụ thuộc vào số lượng hồng cầu bị ký sinh và thời gian kéo dài của bệnh. Do ký sinh trùng sốt rét phát triển, hồng cầu máu bị phá vở hàng loạt, trung tâm sinh huyết bị ức chế làm cho số lượng hồng cầu giảm nhiều, có khi chỉ còn 3 triệu hồng cầu/mm3 máu, huyết cầu tố giảm xuống còn 60-65%; bạch cầu cũng giảm còn 3.000 – 4.000/mm3 máu, bạch cầu đa nhân trung tính giảm theo. Trong các trường hợp bị sốt rét thể ác tính do nhiễm Plasmodium falciparum, triệu chứng thiếu máu thể hiện rõ rệt vì mức độ hồng cầu bị nhiễm ký sinh trùng sốt rét cao, có khi 30% hồng cầu có thể bị ký sinh. Khi số lượng hồng cầu bị phá hủy nhiều, tỷ lệ huyết cầu tố cũng giảm đáng kể gây nên hiện tượng thiếu máu nhược sắc, nhất là sốt rét thể ác tính đái huyết cầu tố. Tuy nhiên ở một số bệnh nhân ghi nhận số lượng bạch cầu có thể tăng, bạch cầu đơn nhân lớn cũng tăng.
Những trường hợp bị bệnh sốt rét nặng và kéo dài, máu còn có một số thay đổi về hóa học như protein, albumin, cholesterol máu đều giảm; trái lại glucose, insulin máu lại tăng.
Ký sinh trùng sốt rét làm thay đổi hồng cầu
 |
KSTSR phá vở hồng cầu |
Ký sinh trùng sốt rét ký sinh trong hồng cầu làm cho hồng cầu bị biến dạng, thay đổi bề mặt hồng cầu, làm thay đổi tính thấm của màng hồng cầu. Chức năng chuyển hóa của hồng cầu bị rối loạn do huyết cầu tố bị phá hủy, các độc tố tạo ra của ký sinh trùng sốt rét và sự đáp ứng miễn dịch của vật chủ tác động lên hồng cầu. Hồng cầu bị ký sinh cũng có những chuyển hóa mới như sự chuyển hóa glucose của ký sinh trùng làm cho nồng độ acid lactic trong hồng cầu tăng lên, hồng cầu phải tăng cường chuyển hóa để điều chỉnh độ pH.
Quan sát bằng kính hiển vi quang học thông thường thấy những hồng cầu nhiễm ký sinh trùng sốt rét Plasmodium falciparum, Plasmodium malariae có hình dạng không thay đổi. Hồng cầu bị nhiễm Plasmodium falciparum có màu sẫm hơn bình thường, có thể thấy những hạt lốm đốm màu tím gọi là hạt Maurer. Hồng cầu bị nhiễm Plasmodium malariae có những hạt nhỏ, mịn gọi là hạt Zieman. Những hồng cầu nhiễm ký sinh trùng sốt rét Plasmodium vivax và Plasmodium ovale bị biến dạng rõ rệt, kích thước phình to lên có thể gấp 1,5 lần đến 4 lần hồng cầu bình thường. Hồng cầu bị nhiễm Plasmodium vivax có màu nhạt, xuất hiện nhiều hạt màu đỏ tím gọi là hạt Schuffner.
Quan sát bằng kính hiển vi điện tử thấy trên màng hồng cầu bị nhiễm ký sinh trùng sốt rét Plasmodium falciparum xuất hiện những nụ lồi. Ký sinh trùng chỉ sau 24 giờ phát triển trong hồng cầu thì những nụ lồi này đã phủ đầy bề mặt hồng cầu. Nụ lồi được tạo thành từ một chất albumin chứa dày đặc electron do chính ký sinh trùng sốt rét tạo ra. Những nụ lồi kết hợp cùng với ái lực kháng nguyên làm cho hồng cầu dính chặt vào nội mạc mao mạch, bám chặt vào thực bào, đồng thời các hồng cầu dính chặt vào nhau tạo thành những thể kết tụ. Đây là một trong những nguyên nhân làm tắc nghẽn các mao mạch nội tạng dẫn đến rối loạn vi tuần hoàn cục bộ các cơ quan, tổ chức.
 | |
Plasmodium falciparum | Plasmodium vivax |
Sốt rét ác tính thể não gây đông máu nội mạch rải rác
Ngoài một số thay đổi về máu đã nêu trên, trong một số trường hợp sốt rét ác tính thể não có thể xuất hiện triệu chứng về rối loạn đông máu như thời gian máu chảy, máu đông, xuất hiện những sản phẩm giáng hóa của fibrinogen trong huyết tương ... Về giải phẩu bệnh lý, một số trường hợp phát hiện thấy những cục máu đông trong các tiểu động mạch và trên cơ sở này đã có quan niệm cho rằng đây là yếu tố khởi phát của các rối loạn thần kinh. Về mặt chức năng, hiện nay đã biết rõ hơn về vai trò của tiểu cầu có chứa rất nhiều hóa chất trung gian như serotonin, histamin ... tham gia trong đáp ứng miễn dịch. Trong phản ứng viêm, trên mặt tế bào nội mô thành mạch xuất hiện các phân tử bám dính, do đó tiểu cầu cũng dễ dính hơn và khởi phát cho quá trình vón tụ rồi hình thành các cục máu đông gây tắc mạch. Khi hiện tượng này xảy ra lan tràn thì sẽ dẫn đến đông máu nội mạch rải rác.
Như vậy, khi bị mắc bệnh sốt rét, triệu chứng thiếu máu và những thay đổi về máu có thể xảy ra với các mức độ khác nhau. Tùy theo trường hợp, cần phát hiện và xử trí kịp thời để khắc phục các biến chứng trầm trọng, góp phần cho việc điều trị bệnh sốt rét đáp ứng hiệu quả.